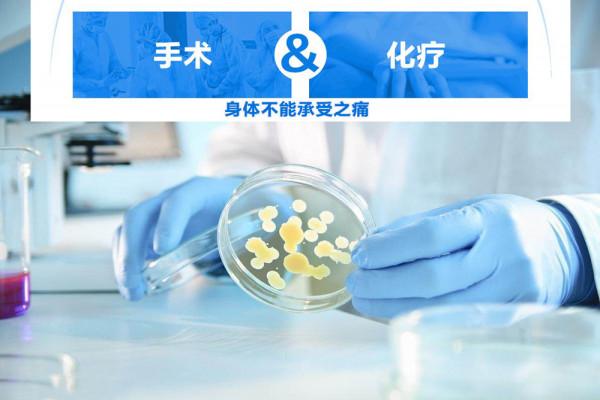
癌症晚期患者:不想活了,真的太痛了!癌痛,究竟是一種什麼感受 癌症晚期患者:不想活了,真的太痛了!癌痛,究竟是一種什麼感受

癌症對於人們來說,雖然不一定就是致命的疾病,但是對於很多人來說依然聞癌色變。因為在確診的那一刻,就預示著要面對一連串的疼痛,如果確診的時候是癌症初期,那麼恭喜你,癌症初期的治癒率是相當高的,基本上就不用忍受之後劇烈的癌痛了。在癌症達到中期或者晚期的時候,癌細胞輕易就會轉移到其他器官,然後引起相當可怕的癌痛。
臨床醫學上,普遍將疼痛分為十個等級,孕婦分娩是可以達到十級疼痛的,可是癌痛竟然高出十級痛苦,遠遠比生孩子疼痛了。癌症的治療過程中最可怕的就是要面對癌痛,如果癌痛不能忍,甚至很多人還出現輕生的念頭,這種痛楚往往讓人無法承受,正常人是無法理解的。
十六歲女孩面對癌痛,強忍著淚水:“我快熬不下去了。”
對很多人來說,十六歲正是花季時候,可是對於蕊蕊來說,卻是噩夢的開始。因為在十六歲的她,被確診為胃癌。一個少女本應該在課堂上學習,在下課後玩耍,在放學回家時享受同伴之間的樂趣,但蕊蕊卻要在醫院待著,每天都在跟癌症打仗。今天跟大家分享這位十六歲女孩的癌症經歷,一起看看她這個癌症患者的自述。
“我快熬不下去了!”蕊蕊每天都會跟自己父母說的話,這句話都快變成她的口頭禪了。其實,在蕊蕊確診為癌症的時候,就已經是癌症晚期了,醫生給出的治療方案是直接化療。化療是很痛苦的,每天都需要將藥物注射進去體內。蕊蕊說:“我每天的感覺都是全身痛,這裡痛,那裡痛。”
注射藥物的時候,我好像感覺到在血管中流動,甚至在口腔、腸胃到肛門,我甚至每個器官都有感覺,那些藥物好像在撕裂我的面板,讓我覺得全身都痛!蕊蕊說到這些話的時候,整個眼睛都是溼潤的,可想而知,在化療的過程中她有多難受,她才只有十六歲啊。
“這種化療的痛,就像一點點地撕裂我的面板,那些藥物一直在流動,在我的身體內一直動來動去。”蕊蕊還說,平時還會覺得很頭暈,有時候覺得不清醒,反正頭痛欲裂的感覺,躺在床上根本不想起來,也沒有力氣起來,誰都不想理,只想自己靜靜地待著。
每每到吃東西的時候,食物要從口腔進入食道,就覺得很痛,而且還有灼熱感,即便是很多天沒胃口不怎麼吃東西了,但是肚子都不會覺得餓,可能是這樣的反應造成胃脹,也許是心理的一種抗拒感吧。更難受的是,化療還會產生脫髮的副作用,蕊蕊現在的頭髮都已經掉到七七八八了。
雖然不怎麼吃東西,但是人體的正常新陳代謝還是需要排便的,可蕊蕊說她很久很久才會排一次便,排便也不順暢便秘得很,每一次都得拉很久才能拉出來,蹲在廁所裡面好久才出來,整個人都好像虛脫一般。蕊蕊覺得最難受的一件事,就是打“升白針”,因為要防止白細胞掉得快,必須要打這個針來平衡白細胞。
“每次打完這個針,我都覺得身體不是自己的,就像被人揍了一頓一樣,渾身都是痛的,坐也不是,站也不是,睡也睡不著,躺著都感覺到骨頭是刺痛的。”還有就是,打完針有時候還會造成全身都瘙癢,即使怎麼撓面板都不止癢,這真是無敵難受。
“其實癌痛是其他人無法理解的,總覺得痛無非就是那樣,最痛的也就是生孩子了吧,但癌痛真的無法用言語形容,就像有東西一直在咬我的面板。”對於蕊蕊來說,死亡是一刻的事,死了就能一了百了,至少不用再承受這種癌痛了,“我分分鐘都想過,要不死了算了。”
尤其是蕊蕊已經是胃癌的晚期了,其實治癒的機率真的非常低,只不過看到父母那麼難受,她自己也不願意放棄治療,至少還是給希望父母和自己,盡力了無法再延續自己的生命,那隻能說是自己的命吧!其實,蕊蕊本來是個陽光女孩,自從確診胃癌晚期之後,她一秒鐘都沒有真正地笑過。
經歷過最痛苦的癌痛,讓她明白到生命真的很重要,她很想自己能活得久一點,但是又不希望這種癌痛繼續折磨她,如果忍受不了癌痛,最後註定死亡,還不如自己體面地離開。“我熬不住了,我想死。”這是大部分癌症晚期病患經歷癌痛時的心聲。
有些癌症患者最後不是因為癌症無法治癒而死亡,更多是因為無法承受癌痛,最後自己選擇離開,至少這樣能少受一些痛苦,這對於他們來說,也許是最期待的治療方式。畢竟癌痛真的不是三言兩語就能夠解說的,沒有經歷過的人,怎能知道到底有多痛呢。
癌痛到底有多痛?比分娩的十級痛楚更恐怖
其他人不是癌症病患,根本就不知道癌痛是什麼東西,聽著別人說難受,其實根本理解不了這種痛苦,到底有多痛。如果將自身承受疼痛分等級,那麼將會分為輕度、中度、重度三個等級:輕度疼痛:只感受到表皮的疼痛感,自身可以接受,而且不會影響生活。
中度疼痛:不能忍受,是那種明顯的疼痛感,患者要吃鎮痛藥物,不然會影響睡眠。重度疼痛:身體完全不能忍受的劇痛,需要長期吃鎮痛藥物來止痛,影響正常生活,睡眠也無法入睡,甚至還會導致神經紊亂,整個身體都處於疼痛之中。
癌痛是屬於重度疼痛的,人們常把分娩列為十級痛楚,也就算是最痛的一種痛感了,但是癌痛是比分娩的十級痛楚更恐怖,可想而知到底有多痛苦了!據調查資料顯示,癌症初期的患者有25%的人會覺得疼痛,中晚期的患者有60%-80%感覺到重度疼痛。
很多人都覺得癌痛就忍忍吧,總會過去的,但是不吃止痛藥是根本活不下去的,畢竟癌痛也算是一種病,需要正規地治療,不然受苦受難的只會是自己。很多癌症患者熬過了治療這個艱難的過程,但卻熬不過癌痛的折磨,最後結束自己的生命。
癌痛有那麼可怕嗎,會產生什麼的影響?
其實,跟平時的疼痛比較,如果是其他疾病引起的疼痛,一般都是短暫的,基本是吃點止疼藥就能把疼痛停止,但是癌痛不能。癌痛是持續的疼痛,它會一直痛,而且疼痛度是不停地增加。當癌痛越來越嚴重的時候,還會對癌症患者產生一些影響。
- 食慾不佳
其實,本身疾病就會引起食慾不振,更何況是癌症,正常的癌痛反應就會導致患者吃不下飯,食量不停地減少,這個症狀是因為癌痛影響的,所以看到很多癌症患者越來越瘦,甚至瘦成皮包骨,不是他們不想吃是根本吃不下。
- 睡眠不好
由於癌痛的影響,患者會睡不好,因為實在太痛了。加上睡眠質量差,睡眠時間也不充足,身體的新陳代謝就會紊亂,本身吃得少吸收的營養少,會導致身體免疫力差,更容易讓癌痛增強得快。
- 煩躁不安
長期的癌痛影響,患者的情緒會不穩定,畢竟癌痛不是單純的疼痛,對身體和精神都是一種折磨,癌症患者甚至會出現抑鬱的情緒,在無法承受癌痛的時候,還會產生輕生的念頭,這也是癌痛給患者帶來的不良影響。
那麼,是什麼原因引起癌痛的
1、化療、放療引起
化療的時候,患者需要打升白針來穩定白細胞,在藥物注射的時候,會先透過骨穿或者其他手術,這類的手術會引起身體的不良反應,而且會伴隨區域性的疼痛,這是因為在化療引起的癌痛。
2、癌症直接引起
在癌症的初期,因為癌細胞會不停地活躍運動,會導致身體出現疼痛感。有些腫瘤在病發初期的時候,會壓迫到身體組織然後引起癌痛。就像肺癌患者,癌細胞會抑制牽引著胸膜,引起嚴重的胸痛。當腫瘤壓迫到神經的時候,會引起頭暈、嘔吐、疼痛感。
3、癌症間接引起
如果癌細胞轉移了,會引起其他部位的疼痛感,比如在癌細胞骨轉移時引起的骨痛。而且癌症因為癌細胞擴散的時候,還可能會導致一系列的併發症,因而引起不同程度的疼痛,這也是無法避免的。
目前,癌痛的治療有哪些嗎?以下4種辦法,瞭解下:
- 區域性放療
有的患者出現癌痛是因為某個病灶引起的,那麼為了防止癌細胞快速擴散,可以透過區域性放療來緩解癌痛,這樣能針對病灶進行治療和緩解。
- 介入治療
不是所有的患者都對鎮痛藥物有效的,有些患者則是對鎮痛藥物不耐受,也就是說對藥物沒有反應,鎮痛效果不那麼好。而且這些鎮痛藥物還會對患者產生不同程度的不良反應,那麼需要介入治療,透過對區域性病灶射頻消融來達到鎮痛的效果。
- 藥物止痛
最簡單的止癌痛辦法是使用鎮痛藥,不過也有分輕度、中度、重度疼痛,三種程度是用不同的藥物。輕度疼痛可用西樂葆、散利痛等;中度疼痛使用可待因、曲馬多等;重度疼痛可以考慮用羥考酮來緩解痛楚。
- 直接化療
對於一些鎮痛藥物不耐受的癌症患者,那麼只能用抗腫瘤治療來緩解癌痛。對於忍痛能力比較好,心理承壓能力較強的患者來說,可用化療縮小腫瘤的大小,從根源上消除腫瘤以免腫瘤變大壓迫神經引起疼痛。
總結:
每個人都希望自己的人生可以健康快樂,但世事難料,有的人就沒有那麼幸運,總會遭到一點命運的不公。如果身體出現問題只能勇敢面對,即使是確診癌症也好,一定要積極地進行抗癌。不過,在癌症治療的過程中,面對疼痛度達到十級的癌痛,確實是很難忍的,因此,正確地接受治療是必須的,不要一昧地忍受癌痛帶來的痛苦,反而應該遵醫囑用適合自己的辦法去應對。希望每一位癌症患者都能夠戰勝癌症,最後收穫健康和長壽。